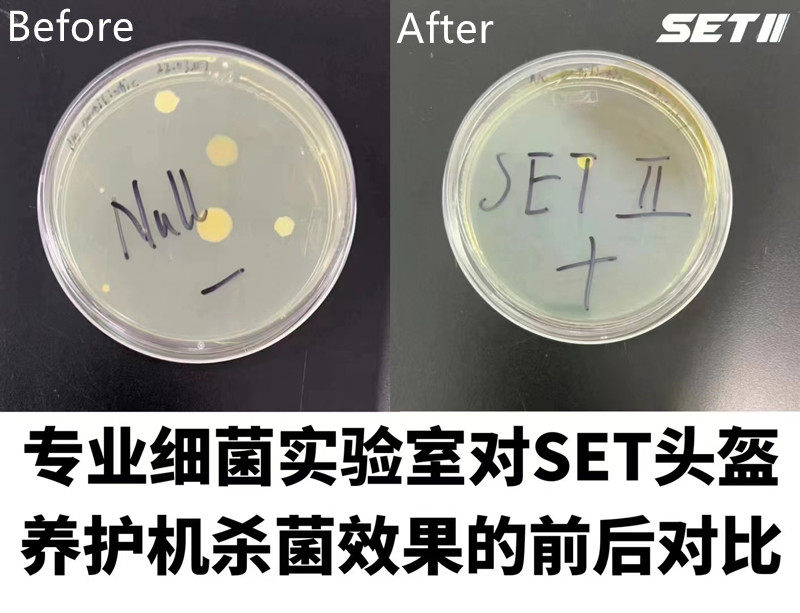

Сушилка для сушилки для сушилки на мотоцикле.

Цена: 2 092-18 888руб. (¥80)
Артикул: 672560705935
Вес товара: ~0.7 кг. Указан усредненный вес, который может отличаться от фактического. Не включен в цену, оплачивается при получении.
Описание товараPGRpdiBzdHlsZT0id2lkdGg6IDc1MC4wcHg7aGVpZ2h0OiAxMzAxNy4wcHg7b3ZlcmZsb3c6IGhpZGRlbjsiPjxkaXYgc3R5bGU9IndpZHRoOiA3NTAuMHB4O2hlaWdodDogMTMwMTcuMHB4O292ZXJmbG93OiBoaWRkZW47Ij48aW1nIHN0eWxlPSJkaXNwbGF5OiBibG9jazt3aWR0aDogMTAwLjAlOyIgc3JjPSJodHRwczovL2ltZy5hbGljZG4uY29tL2ltZ2V4dHJhL2kzLzIxNDE2MTExL08xQ04wMTI2SExYcDF2MHQ2cjVSM0paXyEhMjE0MTYxMTEuanBnIj48aW1nIHN0eWxlPSJkaXNwbGF5OiBibG9jazt3aWR0aDogMTAwLjAlOyIgc3JjPSJodHRwczovL2ltZy5hbGljZG4uY29tL2ltZ2V4dHJhL2kzLzIxNDE2MTExL08xQ04wMUkxM2VFMTF2MHQ2azk5eVptXyEhMjE0MTYxMTEuanBnIj48aW1nIHN0eWxlPSJkaXNwbGF5OiBibG9jazt3aWR0aDogMTAwLjAlOyIgc3JjPSJodHRwczovL2ltZy5hbGljZG4uY29tL2ltZ2V4dHJhL2kxLzIxNDE2MTExL08xQ04wMVpZRmV6SjF2MHQ2aTBUaVpCXyEhMjE0MTYxMTEuanBnIj48aW1nIHN0eWxlPSJkaXNwbGF5OiBibG9jazt3aWR0aDogMTAwLjAlOyIgc3JjPSJodHRwczovL2ltZy5hbGljZG4uY29tL2ltZ2V4dHJhL2kyLzIxNDE2MTExL08xQ04wMUNDcGx2RzF2MHQ2aWdLd0JsXyEhMjE0MTYxMTEuanBnIj48aW1nIHN0eWxlPSJkaXNwbGF5OiBibG9jazt3aWR0aDogMTAwLjAlOyIgc3JjPSJodHRwczovL2ltZy5hbGljZG4uY29tL2ltZ2V4dHJhL2kyLzIxNDE2MTExL08xQ04wMVQ2T3ZXZDF2MHQ2bjhOU0VqXyEhMjE0MTYxMTEuanBnIj48aW1nIHN0eWxlPSJkaXNwbGF5OiBibG9jazt3aWR0aDogMTAwLjAlOyIgc3JjPSJodHRwczovL2ltZy5hbGljZG4uY29tL2ltZ2V4dHJhL2kzLzIxNDE2MTExL08xQ04wMTRmU3lIOTF2MHQ2cDZjZlNxXyEhMjE0MTYxMTEuanBnIj48aW1nIHN0eWxlPSJkaXNwbGF5OiBibG9jazt3aWR0aDogMTAwLjAlOyIgc3JjPSJodHRwczovL2ltZy5hbGljZG4uY29tL2ltZ2V4dHJhL2kyLzIxNDE2MTExL08xQ04wMXBSUUlRUjF2MHQ2aHJvTjJ4XyEhMjE0MTYxMTEuanBnIj48aW1nIHN0eWxlPSJkaXNwbGF5OiBibG9jazt3aWR0aDogMTAwLjAlOyIgc3JjPSJodHRwczovL2ltZy5hbGljZG4uY29tL2ltZ2V4dHJhL2kxLzIxNDE2MTExL08xQ04wMXpiZ2p6UzF2MHQ2amhMcEo2XyEhMjE0MTYxMTEuanBnIj48aW1nIHN0eWxlPSJkaXNwbGF5OiBibG9jazt3aWR0aDogMTAwLjAlOyIgc3JjPSJodHRwczovL2ltZy5hbGljZG4uY29tL2ltZ2V4dHJhL2k0LzIxNDE2MTExL08xQ04wMTBLeE1sNjF2MHQ2alhleGY1XyEhMjE0MTYxMTEuanBnIj48aW1nIHN0eWxlPSJkaXNwbGF5OiBibG9jazt3aWR0aDogMTAwLjAlOyIgc3JjPSJodHRwczovL2ltZy5hbGljZG4uY29tL2ltZ2V4dHJhL2kzLzIxNDE2MTExL08xQ04wMTlRZXBBVTF2MHQ2c21aS2NJXyEhMjE0MTYxMTEuanBnIj48aW1nIHN0eWxlPSJkaXNwbGF5OiBibG9jazt3aWR0aDogMTAwLjAlOyIgc3JjPSJodHRwczovL2ltZy5hbGljZG4uY29tL2ltZ2V4dHJhL2k0LzIxNDE2MTExL08xQ04wMVhsN1hLZTF2MHQ2c21ZdmVuXyEhMjE0MTYxMTEuanBnIj48aW1nIHN0eWxlPSJkaXNwbGF5OiBibG9jazt3aWR0aDogMTAwLjAlOyIgc3JjPSJodHRwczovL2ltZy5hbGljZG4uY29tL2ltZ2V4dHJhL2kzLzIxNDE2MTExL08xQ04wMWNKbmRkdTF2MHQ2amZ6dHRtXyEhMjE0MTYxMTEuanBnIj48L2Rpdj48L2Rpdj4=
Продавец:王大爷爷
Рейтинг:

Всего отзывов:0
Положительных:0
Выберите вариацию / цвет
Добавить в корзину
- Информация о товаре
- Фотографии
| Цвет: | Основное тело, Основное тело+насадка для очистки перчаток, Гигиенические перчатки, трубка, 5 фильтров |